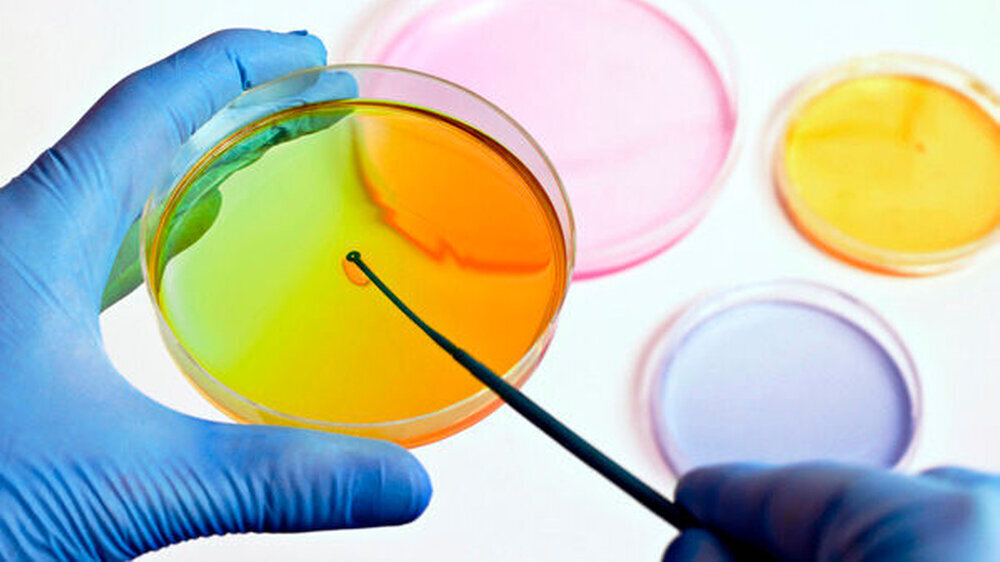

Ethikrat empfiehlt, PID-Verordnung zu verbessern
Am 14. November 2012 verabschiedete das Bundeskabinett den Entwurf einer "Verordnung über die rechtmäßige Durchführung einer Präimplantationsdiagnostik" (PIDV). Danach ist die Bundesregierung ermächtigt, die Verfahrensweisen zur PID zu regeln. Diese Rechtsverordnung bedarf der Zustimmung des Bundesrates.
Rat moniert fehlende Transparenz
Der Ethikrat gibt nun zu bedenken, dass die Vorgaben im Entwurfs nicht reichen und beklagt mangelnde Transparenz und ungenügende Kontrollmöglichkeiten durch den Gesetzgeber, eine fehlende Begrenzung der PID-Zentren und mangelhafte Verfahrensvorgaben für die Ethikkommissionen.
Generell begrüßt der Rat den Vorschlag, dass sich die Länder auf eine bundesweit tätige Zulassungsstelle für PID-Zentren geeinigt haben, weil dadurch am besten die hohen Qualitätsmaßstäbe nach bundesweit einheitlichen Kriterien gewährleistet werden könnten.
Übersicht über alle PID-Fälle
Aus Sicht des Deutschen Ethikrates müssen die Informationspflichten der PID-Zentren an die zentrale Dokumentationsstelle aber so ausgestaltet werden, dass der Gesellschaft und dem Bundestag eine Übersicht über die Anwendung der begrenzten Zulassung der PID und damit gegebenenfalls korrigierendes gesetzgeberisches Handeln möglich sind.
Mehr Informationen und dezidierte Begründungen
Die in der jetzigen Fassung zusätzlich eingeführte Meldung des Vererbungsmodus einer Krankheit (Chromosomenstörung, autosomal-dominant, autosomal-rezessiv und geschlechtsgebunden) reiche dazu nicht aus.
Vielmehr seien für den ersten Begründungstyp zur Durchführung einer PID (hohes Risiko einer schwerwiegenden Erbkrankheit für die Nachkommen) Informationen über die Erkrankungswahrscheinlichkeit der Nachkommen und die zu erwartende Krankheitsausprägung erforderlich. Im Hinblick auf den zweiten Typ (hohe Wahrscheinlichkeit einer Tot- oder Fehlgeburt) müsse dargelegt werden, dass und wie wahrscheinlich eine schwerwiegende Schädigung des Embryos zu erwarten ist.
Einer Indikationsliste entgegen steuern
Auf diese Weise könne man mittelbar einer Indikationsliste entgegenwirken, ohne dem Bundestag die Kontrollmöglichkeit über eine nicht dem gesetzgeberischen Willen entsprechende Verschiebung der Grenzen bei der PID-Anwendung zu entziehen.
Der Ethikrat hält zudem die Begrenzung auf drei Zentren für wünschenswert, was bedeute, dass nicht alle Einrichtungen, die die Qualitätsanforderungen erfüllen, wie derzeit in der Verordnung vorgesehen, zugelassen werden können.
Der Vorschlag des Bundes beschränke sich auf eine nur rahmenhafte Festlegung der Zusammensetzung der Ethikkommissionen; die genaue Regelung der Zusammensetzung, der Berufung, des internen Verfahrens und der Finanzierung der Ethikkommissionen bleibe den Ländern überlassen. Dies berge die Gefahr uneinheitlicher Regelungen und Entscheidungspraktiken.
Diese geringe Regelungsdichte sei vor dem Hintergrund der durch eine PID betroffenen Grundrechte nicht ausreichend. Davon unabhängig könne eine weitere Festlegung der Kommissionsverfahren nicht durch Selbstverwaltungskörperschaften erfolgen, da die diese Bereiche zumindest durch die Landesgesetzgeber geregelt werden müssten.